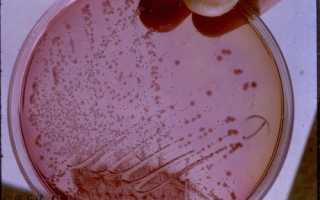
Чем опасен фекальный энтерококк при беременности, лечение и профилактика

Фекальный энтерококк — микроорганизм, представляющий угрозу для здоровья беременных женщин и их детей. Во время беременности иммунная система ослаблена, что увеличивает риск инфекций. В статье рассмотрим опасности фекального энтерококка, его локализацию, последствия, а также методы лечения и профилактики. Это поможет будущим мамам своевременно реагировать на угрозу и сохранить здоровье.
Что такое фекальный энтерококк при беременности?
Enterococcus faecalis во время беременности требует немедленного медикаментозного вмешательства. Условно-патогенные микроорганизмы, под воздействием различных факторов, начинают активно размножаться и перемещаться из кишечника в мочевыводящую систему. Женщина может заподозрить наличие проблемы по следующим симптомам:
- изменение цвета мочи;
- повышенная утомляемость;
- болезненные ощущения и рези при мочеиспускании;
- выделения беловато-зеленого цвета из уретры;
- ослабление оргазма во время половых актов;
- учащенные позывы к мочеиспусканию;
- развитие депрессивных состояний;
- чувство слабости;
- снижение либидо.
Беременная женщина, у которой обнаружены условно-патогенные микроорганизмы, представляет опасность для своего ребенка, так как может стать источником заражения фекальными энтерококками. Это может произойти в следующих случаях:
- при прохождении плода через родовые пути;
- во время грудного вскармливания;
- при проведении санитарно-гигиенических процедур.
Взрослые и дети могут заразиться фекальным энтерококком в любом медицинском учреждении. В группу риска попадают пациенты с повреждениями кожи и слизистых, нарушениями обмена веществ, дисбалансом кишечной микрофлоры и ослабленным иммунитетом.
Фекальный энтерококк представляет собой потенциально опасный микроорганизм, особенно для беременных женщин. Эксперты подчеркивают, что его присутствие может привести к серьезным осложнениям, включая инфекции мочевыводящих путей и сепсис. Важно отметить, что фекальный энтерококк может негативно сказаться на здоровье плода, вызывая преждевременные роды или другие патологии. Лечение обычно включает антибиотики, однако выбор препарата должен быть осторожным, чтобы избежать негативного воздействия на развивающийся организм. Профилактика заключается в соблюдении правил личной гигиены, тщательной обработке продуктов питания и регулярном медицинском обследовании. Беременным женщинам рекомендуется быть особенно внимательными к своему здоровью и обращаться к врачу при первых признаках инфекции.

Где могут обнаружить бактерию?
Фекальную условно-патогенную бактерию можно выявить только в ходе лабораторной диагностики. У пациенток, находящихся на любом сроке беременности, осуществляется забор биологического материала. Чаще всего у будущих мамочек микроорганизмы выявляются в урине, так как они заселяют мочеполовую систему, провоцируя развитие воспалительных процессов. Если у пациентки отсутствует ярко выраженная клиническая картина патологии, у нее выявляют в ходе лабораторных исследований не меньше 100 тыс. ед. в 1 кубический см свежей урины.
Важно! Когда у беременной женщины начинает проявляться характерная симптоматика, либо при заборе урины посредством катетера, произойдет снижение диагностического порога.
Фекальные энтерококки обитают в кишечнике человека. Они входят в состав местной микрофлоры и принимают активное участие в пищеварительном процессе и формировании кишечного иммунитета. Условно-патогенные бактерии способны на протяжении длительного промежутка времени находиться в воздухе, из-за чего происходит заражение людей. Они обладают высокой устойчивостью к агрессивным средам и медикаментам, поэтому процесс лечения может затянуться из-за частой коррекции схемы терапии.
Даже при применении самых современных и эффективных лекарственных препаратов полностью избавиться от условно-патогенных микроорганизмов не удастся. В ходе комплексной медикаментозной терапии можно существенно сократить колонии фекальных энтерококков и в дальнейшем держать их под контролем.
| Опасность фекального энтерококка при беременности | Лечение | Профилактика |
|---|---|---|
| Инфекции мочевыводящих путей (цистит, пиелонефрит) – могут привести к преждевременным родам, низкой массе тела новорожденного, сепсису у матери и ребенка. | Антибиотики (цефалоспорины, аминогликозиды, ванкомицин – выбор препарата зависит от чувствительности к антибиотикам) | Соблюдение правил личной гигиены (частое мытье рук, особенно после посещения туалета); тщательное мытье продуктов питания; избегание контакта с фекалиями; своевременное лечение инфекций мочевыводящих путей и других инфекций. |
| Эндометрит (воспаление слизистой оболочки матки) – может привести к осложнениям после родов, сепсису. | Антибиотики (широкий спектр действия, выбор зависит от чувствительности к антибиотикам) | Профилактика инфекций во время родов (соблюдение стерильности); своевременное лечение любых инфекций. |
| Сепсис (заражение крови) – опасное для жизни состояние, как для матери, так и для ребенка. | Антибиотики (внутривенно), интенсивное лечение в стационаре. | Соблюдение правил личной гигиены; профилактика инфекций. |
| Преждевременные роды | Лечение направлено на предотвращение преждевременных родов и сохранение беременности (в зависимости от состояния). | Соблюдение режима отдыха, избегание стрессовых ситуаций, своевременное лечение инфекций. |
| Внутриутробное инфицирование плода | Лечение зависит от тяжести состояния и может включать антибиотики. | Своевременное лечение инфекций у беременной. |
| Послеродовые инфекции | Антибиотики, симптоматическое лечение. | Соблюдение правил асептики и антисептики во время родов и послеродового периода. |
Интересные факты
Вот несколько интересных фактов о фекальном энтерококке и его опасности при беременности:
-
Риск инфекций: Фекальный энтерококк (Enterococcus faecalis и Enterococcus faecium) может вызывать различные инфекции, включая инфекции мочевыводящих путей и эндометрит. У беременных женщин это может привести к серьезным осложнениям, таким как преждевременные роды или инфекции у новорожденного.
-
Антибиотикорезистентность: Некоторые штаммы энтерококков обладают высокой устойчивостью к антибиотикам, что затрудняет лечение инфекций, вызванных этими бактериями. Это особенно опасно для беременных женщин, так как ограниченный выбор безопасных антибиотиков может привести к необходимости использования менее эффективных или более токсичных препаратов.
-
Профилактика через гигиену: Профилактика инфекций, связанных с фекальным энтерококком, включает в себя строгие меры гигиены, такие как регулярное мытье рук, особенно после посещения туалета и перед едой. Это особенно важно для беременных женщин, так как поддержание хорошей гигиены может снизить риск заражения и защитить как мать, так и ребенка.

Чем опасна инфекция для плода?
Во время беременности организм женщины становится более уязвимым к различным инфекциям. Фекальный энтерококк может вызвать воспалительные процессы в мочевыводящих путях. Это связано с тем, что в теле будущей мамы создаются естественные условия для активного размножения условно-патогенной микрофлоры и застоя мочи. Кроме того, гормональный дисбаланс также влияет на развитие бактериурии.
Согласно медицинской статистике, фекальный энтерококк у беременных женщин выявляется в 5 раз чаще, чем у обычных пациенток.
Увеличение количества колоний фекального энтерококка может привести к возникновению и усугублению таких заболеваний, как:
- бактериемия;
- пищевые отравления;
- менингит;
- дисбактериоз;
- бактериальный эндокардит и другие.
Какие терапевтические меры предпринимают при беременности?
Чтобы выявить фекальный энтерококк при беременности, будущим мамочкам придется пройти лабораторное обследование. Им необходимо сдать для исследований разный биологический материал, в котором специалисты смогут выявить патогенные штаммы бактерий:
- кровь;
- урину;
- мазок;
- фекалии.
После лабораторных исследований врачи смогут поставить точный диагноз и разработать индивидуально для каждой пациентки схему медикаментозной терапии. Если в лечении будет нуждаться грудничок, то для него подберутся эффективные и безопасные бактериофаги. Взрослых больных обычно лечат посредством:
- антибактериальных препаратов (таблеток, уколов, суппозиторий);
- местных средств: гелей, мазей;
- витаминно-минеральных комплексов;
- физиотерапевтических процедур.
Внимание! При лечении беременных женщин не применяются антибиотики. Специалисты для будущих мамочек подбирают бактериофаги, которые не способны нанести вред развивающемуся плоду.

Профилактика заражения
Для того чтобы предотвратить активное размножение условно-патогенной микрофлоры, будущим мамам следует регулярно осуществлять профилактические меры:
- соблюдать правила интимной гигиены;
- мыть руки перед каждым приемом пищи, после прогулок, посещения туалета и контакта с домашними животными;
- избегать использования чужого нижнего белья, общих полотенец, бритвенных принадлежностей и зубных щеток;
- применять барьерные средства контрацепции во время интимной близости;
- иметь одного постоянного партнера;
- не заниматься нетрадиционными видами секса в период беременности;
- использовать стерильные наборы при сдаче гинекологических анализов.
Заключение
Беременные женщины должны с регулярной периодичностью сдавать множество анализов, благодаря чему специалисты могут контролировать их состояние, своевременно выявлять любые отклонения от нормы. У такой категории пациенток чаще выявляются в урине условно-патогенные бактерии, которые способны при увеличении колоний привести к выкидышу или осложнениям при родах. Минимизировать риски будущие мамочки смогут в том случае, если еще до зачатия пройдут скрининговое обследование, благодаря которому своевременно устранят все патологические процессы в организме.
Симптомы инфекции у беременных женщин
Фекальный энтерококк, являющийся частью нормальной микрофлоры кишечника, может стать причиной серьезных инфекций, особенно у беременных женщин. Инфицирование этим микроорганизмом может проявляться различными симптомами, которые важно распознать на ранних стадиях для предотвращения осложнений как для матери, так и для плода.
Одним из первых симптомов инфекции является повышение температуры тела. Беременные женщины могут испытывать лихорадку, которая может быть как легкой, так и высокой. Это состояние часто сопровождается ознобом и потоотделением.
Другим распространенным симптомом является боль в животе. Женщины могут ощущать спазмы или дискомфорт в области живота, что может быть связано с воспалительными процессами в кишечнике. Важно отметить, что такие боли могут быть схожи с обычными болями при беременности, поэтому необходимо внимательно следить за их характером и интенсивностью.
Диарея также является частым признаком инфекции, вызванной фекальным энтерококком. Она может быть как легкой, так и тяжелой, и в некоторых случаях может привести к обезвоживанию, что особенно опасно для беременных женщин. Важно следить за частотой стула и консистенцией, так как это может помочь в диагностике.
Кроме того, беременные женщины могут испытывать общую слабость и утомляемость. Эти симптомы могут быть связаны как с инфекцией, так и с изменениями в организме, вызванными беременностью. Однако, если слабость сопровождается другими симптомами, это может указывать на необходимость медицинского вмешательства.
Некоторые женщины могут также заметить изменения в аппетите, включая его снижение или полное отсутствие. Это может быть связано с дискомфортом в животе или общим недомоганием. Важно поддерживать адекватное питание и гидратацию в этот период.
В редких случаях инфекция может привести к более серьезным осложнениям, таким как сепсис, который требует немедленного медицинского вмешательства. Поэтому при появлении любых из перечисленных симптомов беременным женщинам настоятельно рекомендуется обратиться к врачу для диагностики и назначения соответствующего лечения.
Вопрос-ответ
Как фекальный энтерококк влияет на здоровье беременной женщины?
Фекальный энтерококк может вызывать инфекции мочевыводящих путей и другие бактериальные инфекции, что может негативно сказаться на здоровье беременной женщины. Это может привести к осложнениям, таким как преждевременные роды или инфекции, которые могут повлиять на развитие плода.
Какие симптомы могут указывать на инфекцию, вызванную фекальным энтерококком?
Симптомы могут включать боль или жжение при мочеиспускании, частые позывы к мочеиспусканию, а также общие признаки инфекции, такие как лихорадка, усталость и боли внизу живота. Если у беременной женщины возникают такие симптомы, необходимо обратиться к врачу для диагностики и лечения.
Как можно предотвратить заражение фекальным энтерококком во время беременности?
Для профилактики заражения важно соблюдать правила личной гигиены, такие как регулярное мытье рук, особенно после посещения туалета и перед едой. Также стоит избегать употребления неочищенной воды и сырой пищи, а также следить за состоянием здоровья и проходить регулярные медицинские осмотры.
Советы
СОВЕТ №1
Обязательно проходите регулярные медицинские обследования во время беременности. Это поможет своевременно выявить возможные инфекции, включая фекальный энтерококк, и начать лечение на ранних стадиях.
СОВЕТ №2
Соблюдайте правила личной гигиены, особенно после посещения туалета и перед едой. Тщательное мытье рук с мылом поможет снизить риск заражения фекальным энтерококком и другими патогенами.
СОВЕТ №3
Обратите внимание на качество пищи и воды, которую вы употребляете. Избегайте употребления сырых или недостаточно термически обработанных продуктов, а также неочищенной воды, чтобы минимизировать риск инфекций.
СОВЕТ №4
Если у вас есть подозрения на инфекцию или вы заметили необычные симптомы, такие как диарея или боли в животе, немедленно обратитесь к врачу. Раннее обращение за медицинской помощью поможет избежать осложнений и защитить здоровье как ваше, так и вашего ребенка.